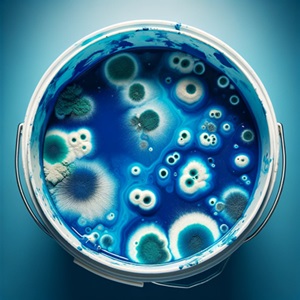
Schimmelbefall in Farbeimern Schimmelbefall in Farbeimern

Schimmel und seine Farben: Ein umfassender Leitfaden
Einführung in die Welt der Schimmelpilze
Schimmelpilze sind Mikroorganismen, die in verschiedenen Umgebungen vorkommen und eine Vielzahl von Farben aufweisen können. Sie spielen eine wesentliche Rolle im Ökosystem, können jedoch in Wohnräumen gesundheitliche Probleme verursachen.
Die Vielfalt der Schimmelfarben
Weißer Schimmel: Der stille Eindringling
Weißer Schimmel ist oft das erste Anzeichen eines größeren Schimmelproblems. Er kann auf Oberflächen wie Holz, Tapeten und Leder auftreten und ist manchmal schwer zu erkennen, da er wie harmlose Staubschichten aussieht.
Schwarzer Schimmel: Ein Gesundheitsrisiko
Schwarzer Schimmel, wissenschaftlich als Stachybotrys chartarum bekannt, ist besonders gefährlich für die Gesundheit. Er produziert Mykotoxine, die bei Menschen Atemwegsprobleme und allergische Reaktionen auslösen können.
Grüner Schimmel: Der häufige Gast
Grüner Schimmel tritt häufig in feuchten Umgebungen auf und ist oft auf Lebensmitteln, Wänden oder in Bädern zu finden. Er kann verschiedene Schattierungen haben, von hellgrün bis dunkelgrün.
Ursachen und Prävention von Schimmelbildung
Feuchtigkeit ist der Hauptfaktor für Schimmelwachstum. Eine gute Belüftung, regelmäßige Reinigung und die Kontrolle der Luftfeuchtigkeit sind entscheidend, um Schimmelbildung zu vermeiden.
Maßnahmen bei Schimmelbefall
Bei einem Schimmelbefall ist schnelles Handeln gefragt. Betroffene Bereiche sollten umgehend gereinigt und saniert werden, um eine Ausbreitung zu verhindern und die Gesundheitsrisiken zu minimieren.
Schimmel in Farbeimern: Erkennung und Handlungsempfehlungen
Schimmelbildung in Farbeimern ist ein Problem, das nicht nur die Farbqualität beeinträchtigt, sondern auch gesundheitliche Risiken bergen kann. Hier sind einige Schritte, die man beachten sollte:
Erkennung von Schimmel in Farbeimern
- Sichtbare Schimmelsporen oder -flecken.
- Unangenehmer, modriger Geruch.
- Veränderung der Farbkonsistenz oder Klumpenbildung.
Handlungsempfehlungen bei Schimmelbefall in Farbeimern
- Entsorgung der kontaminierten Farbe: Nicht verwenden und gemäß den Vorschriften entsorgen.
- Reinigung des Eimers: Mit einer Bleichlösung reinigen.
- Trocknung: Eimer vollständig trocknen.
- Lagerbedingungen überprüfen: Trocken, kühl und gut belüftet lagern.
- Überprüfung anderer Behälter: Um Kreuzkontamination zu vermeiden.
- Konservierungsmittel: Können bei Langzeitlagerung hilfreich sein.
Durch die Bereitstellung dieses umfassenden Leitfadens möchten wir das Bewusstsein für die Problematik von Schimmel in Wohnräumen sowie in Farbeimern schärfen und effektive Strategien zur Bekämpfung und Prävention aufzeigen.
✔️ Bis zu 6 Räume
✔️ Original airself
✔️ Schimmelpilzgattungen
✔️ Belastungseinschätzung
✔️ 1 Laboranalyse
✔️ Original airself